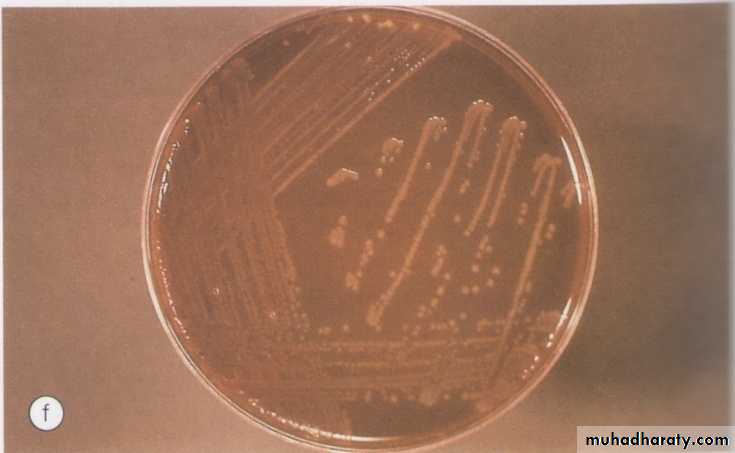

10/31/2011
1Good afternoon
Cornea10/31/2011
2Anatomy
The cornea consists of the following layers:1- Epithelium : is stratified, squamous, non-keratinized.
2- Bowman layer: is the acellular superficial layer of the stroma.
3- The stroma: makes up 90% of corneal thickness.
4- Descemet membrane : is composed of a fine latticework of collagen fibrils.
5- The endothelium : consists of single layer of hexagonal cells that can not regenerates. It plays a vital role in maintaining corneal deturgescence.
10/31/2011
3
10/31/2011
4Layers of the cornea
Magnified view : Epithelium and stroma
10/31/20115
Corneal endothelium/ Specular microscopy
10/31/2011
6Why the cornea is transparent ?
1- Regularly oriented collagen fibers.2- Avascular tissue.
3-Unmylinated nerve fibers.
4- Non-keratinized epithelium.
5- Lack of pigments.
6- Role of the endothelium to create a state of relative corneal dehydration.
10/31/2011
7
The cornea is the main refractive elements of the eye accounting for about two-thirds of the total refractive power ( which is about 45 Diopters)., The remaining one-third (which is about 15 D) element from the lens, thus the total refractive power of the eye equal to about 60 D.
The average corneal diameter 11.5 mm vertical and 12 mm horizontal.
10/31/2011
8Bacterial Keratitis
10/31/20119
Pathogens
Bacterial keratitis is very uncommon in normal eye and usually only develops when ocular defenses have been compromised.10/31/2011
10The most common pathogens are :
1. Pseudomonas aeruginosa: Gram negative bacillus (rod ) that flourishes in soil , vegetation , and moist situations in the hospital environment .Its also a commenseal of gastrointestinal tract .2. Staphylococcus aureus : a common Gram positive and coagulase positive commenseal of nares , skin and conjunctive
3. Streptococcus pneumonia : Gram positive commenseal of upper respiratory tract , and infection with it is usually very aggressive .
10/31/2011
11Bacteria that penetrate an apparently normal corneal epithelium are:
1- N. gonorrhea2- N. meningitides
3- C. diphtheriae4- H.influanzae
10/31/201112
Corneal ulcer
10/31/2011
13
A big corneal ulceration with corneal infiltrates all around
Corneal ulcer10/31/2011
Single attack, not involving visual axis.
Recurrent attacks with involvement of visual axis.14
Peripheral corneal ulcers
10/31/2011
15Gram positive cocci Streptococcus Pneumoniae
10/31/2011
16Gram negative cocci N. gonorrhea
10/31/2011
17Gram positive rods
10/31/2011
18Gram negative rodsPseudomonas aeruginosa
10/31/2011
19
Risk Factors
contact lens wear ,particularly soft contact lens worn overnight ,is the most important risk factor for bacterial keratits , Pseudomonas spp. account for 60% of cases . Infection is more likely if there is poor lens hygiene but it can also occur even with apparently meticulous lens care and with daily disposable lenses Bacteria may multiply in the contact lens case where they are protected from disinfection by bacterial biofilm .10/31/2011
20
A corneal epithelium compromised by hypoxia and trauma is also susceptible to infection .
A diagnosis of bacterial keratits must be considered in any contact lens user with acute painful red eye .Trauma: such as accidental injury, surgical(refractive surgery ) , and loose sutures .In developing countries agricultural injury is the major risk factor for developing corneal infection .
Ocular surface disease : such as Herpetic keratitis , Bullous keratopathy ,dry eye , chronic blepharitis , Trichiasis ,exposure , sever allergic eye disease and corneal anesthesia .
Other factors include topical and systemic immunosuppression , diabetes , vitamin A deficiency and measles
10/31/2011
21Bacterial keratitis
Predisposing factorsContact lens wear
Chronic ocular surface disease
Corneal hypoaesthesia
Expanding oval, yellow-white,
dense stromal infiltrate
Stromal suppuration and
hypopyon
Treatment
- topical ciprofloxacin 0.3% or ofloxacin 0.3%
10/31/2011
22Diagnosis
Clinical features:History –pay attention to risk factors
Presenting symptoms : pain , photophobia ,blurred vision and discharge .10/31/2011
23
10/31/2011
24Microbiology
Taking samples.Gram Staining
Culture media:
Blood agar : is suitable for most bacteria & fungi except Nisseria and Haemophilus.
Chocolate agar: used to isolate Nisseria , Haemophilus and Maraxella spp.Cooked meat broth: for anaerobics.
Brain-Heart infusion: for most aerobic bacteria and fungi.
Additional examination should include Ziehl-Nielson stain & Lowestain-Jensen media.
10/31/2011
2510/31/2011
26
Signs:
Epithelial defect with enlarging infiltrate with stromal edema and hypopyon.progressive ulceration may lead to corneal perforation and endophthalmitis.
10/31/2011
27
Sensitivity report
Susceptible: the organism is sensitive to normal dose of antimicrobial agent.Intermediate: the organism is likely to be sensitive to high dose of antimicrobial agent.
Resistant: the organism not sensitive to the antimicrobial agent at the tested dose.
10/31/2011
28Treatment
Bacterial keratitis has the potential to progress rapidly to corneal perforation, even small axial lesion can cause surface irregularity that can lead to significant visual loss. Topical therapy can achieve high tissue concentration and initially should involve broad spectrum antibiotics to cover most common pathogens.10/31/2011
29
Dual therapy
Emperic :topical fortified antibiotics.
combination of two fortified antibiotics (Amino glycosides & Cephalosporin).Monotherapy : by fluroquinolones e.g. ciprofloxacin 0.3% .Topical antibiotics are initially instillated at hourly interval for 24-48 hours, the frequency can be reduced to two hourly for a further 48 hours , treatment is continued until the epithelium has healed.
10/31/2011
30
If no response to empiric therapy: consider
1-antibiotic resistance( change regimen based on culture results).2-poor compliance(admit to hospital).
3- Anesthetic abuse.
10/31/2011
31
Oral antibiotics
Ciprofloxacin 750 mg twice daily for 7-10 days indicated for threatened or acute corneal perforation , peripheral ulceration in which there is scleral extension , oral therapy is also indicated for isolates for which there are potential systemic complication ( N. meningitides).Topical cycloplegic.
Topical steroid { should be avoided until improvement is noted (usually after 48-72 hours) , then dosed at lower frequency than topical antibiotic}.
Subconjunctivial antibiotics are indicated only if there´s poor compliance with topical medications .
10/31/2011
32Causes of failure
Incorrect diagnosis .
Inappropriate choice of antibiotics.
Drug toxicity.
10/31/2011
33complications
Spread to adjacent structures: like sclera in Pseudomonas, or to intraocular (which is rare in absence of corneal perforation); filamentous fungi may penetrate intact Descemet membrane.Corneal damage:scarring,neovascularization, corneal edema,descematocele and perforation.
Synechiae and secondary glaucoma.
Cataract.
10/31/2011
34
MCQ sample
All of the following pathogen able to penetrate intact corneal epithelium , include all of the following, except:1- N. gonorrhea
2- Acanthamoeba spp
3- C. diphtheriae
4- H.influanzae
5- N. meningitides.10/31/2011
35